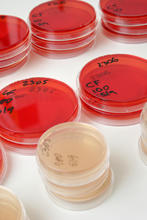

Wright State University honored more than 1,700 graduates during its Fall 2013 Commencement ceremony Dec. 14 in the Wright State Nutter Center.
News
Newsletters
- College of Graduate Programs and Honors Studies Newsletter—January 2024
- College of Graduate Programs and Honors Studies Newsletter—December 2023
- College of Graduate Programs and Honors Studies Newsletter—November 2023
- View all Newsletters
Sign Up for Our Newsletter
Opt-in to receive our newsletter via email.
News from the Wright State University Newsroom
Dec 14, 2013
Wright State University President David R. Hopkins challenged graduates at the 2013 Fall Commencement to prove themselves “mentally strong” in the future. “We want to prepare you to have not only the intellectual capabilities but the mental strength to deal …
Dec 9, 2013
Wright State graduates will celebrate their accomplishments, and those of a university that prides itself on extending the ladder of educational opportunity, during the 2013 Fall Commencement on Saturday, Dec. 14, at the Nutter Center.
Dec 6, 2013
Morgan Ruppert had devoted a few minutes to unsuccessfully attempting to inflate a round blue pool float when she realized a small hole in the ring had been negating her efforts.
Oct 21, 2013
The pending implementation of the controversial healthcare reform law may have shut down federal government, but it stirred Larry Ream to action.
Oct 14, 2013
Wright State University’s Raj Soin College of Business has been named among the best business schools in the nation by The Princeton Review, winning the honor for the fifth year in a row.
Sep 12, 2013
The President’s Awards for Excellence for 2013 in the Staff and Outstanding Unit categories have been announced. Click the links to learn more...
Aug 14, 2013
In today’s world, many individuals and groups have threatened to attack the United States with biological weapons. They have targeted laboratories, biotech...
Jul 11, 2013
Wright State’s Instructional Design for Online Learning certificate program helps college faculty, K–12 teachers and corporate trainers develop effective online courses.
Jul 11, 2013
Imagine standing alone in the pitch black Amazon jungle unable to see your hand inches in front of your face, but acutely aware of the symphony of...